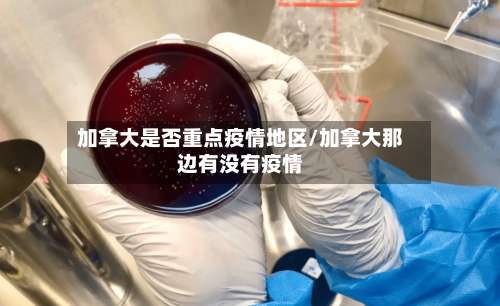
加拿大是否重点疫情地区/加拿大那边有没有疫情-第1张图片

加拿大是否重点疫情地区/加拿大那边有没有疫情
比新冠可怕!全球20国出现原因不明神秘疫情,马来西亚也中招
全球范围内出现了一种原因不明的儿童急性肝炎疫情 ,已波及至少20个国家,造成至少4人死亡,主要感染群体为10岁以下儿童 ,且部分病例病情严重需肝脏移植。以下是具体信息:疫情概况感染规模:世界卫生组织(WHO)统计,全球至少228例确诊病例,覆盖超20个国家,另有50例正在调查中 。
变异新冠病毒在全球多国传播 ,导致多国港口拥堵严重,部分国家港口情况尤为突出,货主和货代需警惕目的港弃货风险并采取应对措施。

印度疫情失控 ,其变异病毒已在全球多国引发输入病例,导致全球疫情形势更加严峻。具体如下:香港航班53人确诊,触发熔断机制4月4日 ,一架自印度新德里起飞的Vistara航空航班抵达香港,机上乘客按要求接受21天隔离 。隔离期间,陆续有乘客确诊感染印度变异新冠病毒 ,未到隔离期结束已有53人确诊。
神秘肝炎疫情概况疫情范围:截至近来,全球17个国家报告200余例儿童不明原因肝炎病例,主要集中于欧洲 ,其中英国病例比较多(145例),美国、西班牙 、以色列、法国、日本等国也有确诊。
及时就医:如果检测结果为阳性,或症状较为严重,如出现呼吸困难 、胸痛、意识模糊等情况 ,应及时前往医院就诊,并告知医生自己的旅行史和接触史。保持良好心态正确认识疫情:新冠病毒的传播已经不是第一次,未来全球范围内新冠病毒传播可能会反复出现 。

加拿大被中国列入低风险国家,入境政策再放宽
〖壹〗、加拿大被中国列为“低风险”国家 ,且其入境政策进一步放宽,具体信息如下:加拿大被中国列为“低风险 ”国家 中国外交部印发《关于公布海外旅行安全风险等级的通知》,对全球各国旅行风险进行评估 ,风险等级分为红色、橙色 、黄色和蓝色四种,分别对应不同程度的旅行风险。
〖贰〗、中国将加拿大列为“低风险”国家,加拿大同步放宽入境政策 ,中加往来便利性显著提升。中国对加拿大的旅行风险评级调整评级结果:中国外交部最新公布的海外旅行安全风险等级中,加拿大被列为蓝色“低风险”国家 。
〖叁〗、针对旅行风险等级为蓝色的国家和地区,外交部无相关安全提醒。加拿大属于蓝色风险等级之列 ,即低风险国家。加拿大放宽入境政策的具体措施针对完全接种疫苗的旅行者:从4月25日开始,他们在入境时将不再需要隔离 。
北美疫情防控升级:美国暂时禁止入境!加拿大确诊第4例!
北美地区疫情防控升级,美国采取多项严格措施,加拿大确诊第4例新型冠状病毒患者。美国疫情防控措施 宣布进入公共卫生紧急状态美东时间1月31日下午 ,白宫宣布美国进入公共卫生紧急状态。
美国移民政策调整的直接背景:疫情与就业压力特朗普于2020年4月20日宣布签署行政令,以“应对新冠病毒袭击 ”和“保护美国公民就业”为由,暂停移民入境美国 。这一决策的直接诱因包括:失业率飙升:美国各州因疫情封锁导致就业市场崩溃 ,失业人口占比达15%,至少2200万人失业,10年来就业率首次下跌。
美国医疗体系有一定基础 ,但在疫情大规模爆发时,也出现了医疗资源紧张的情况,如呼吸机 、防护用品等短缺。而且美国在疫情防控和医疗资源调配方面存在诸多问题 ,并非如文中描述的那样简单 。关于病毒发源地的描述 文中说有几个确诊病人没去过中国甚至加拿大,就质疑病毒发源地,这是不科学的。
重磅!NB省正式宣布解封!加拿大全国重启迹象明显
〖壹〗、加拿大新不伦瑞克省(NB省)宣布解封 ,加拿大全国呈现重启迹象,加航计划恢复部分中国航线。NB省解封情况宣布解封:NB省突然宣布解封,成为加拿大首个采取此举措的省份。疫情数据:截至发稿前,NB省累计确诊118例 ,仅存11例未治愈,已连续一周0增长,全省0死亡 。解封措施:允许不同家庭相互聚会。
中国将加拿大列入旅行“低风险”国家,加拿大放宽入境政策!
〖壹〗、加拿大被中国列为“低风险 ”国家 ,且其入境政策进一步放宽,具体信息如下:加拿大被中国列为“低风险”国家 中国外交部印发《关于公布海外旅行安全风险等级的通知》,对全球各国旅行风险进行评估 ,风险等级分为红色 、橙色、黄色和蓝色四种,分别对应不同程度的旅行风险。
〖贰〗、针对旅行风险等级为蓝色的国家和地区,外交部无相关安全提醒 。加拿大属于蓝色风险等级之列 ,即低风险国家。加拿大放宽入境政策的具体措施针对完全接种疫苗的旅行者:从4月25日开始,他们在入境时将不再需要隔离。
〖叁〗 、加拿大被中国列入“低风险”国家,入境政策再放宽 近日 ,中国外交部印发了《关于公布海外旅行安全风险等级的通知》,对全球各国的旅行风险进行了重新评估 。在此次评估中,加拿大的风险等级被定为蓝色,即“低风险 ”国家。
外贸企业注意!出口到这些地区风险急剧上升
外贸企业需警惕出口到亚洲(尤其是印度)、拉丁美洲(特别是巴西)、欧洲部分国家 、北美洲(美国)、非洲部分国家及大洋洲(澳大利亚)的风险急剧上升。具体分析如下:亚洲地区 4-5月 ,亚洲地区报损案件数量及金额均居全球首位,同比分别增长约250%和258%,出险率仅次于拉丁美洲 。
外贸企业需重点防范的风险类型货款拖欠风险:受经济动荡影响 ,巴西进口商可能因资金链断裂或汇率损失而拖延付款,甚至直接违约。货物滞港风险:港口罢工导致清关延迟,货物长期滞留可能产生高额滞期费 ,增加企业成本压力。
美国和加拿大的风险都显著增加了;大洋洲也没好到哪里去,报损金额同比增长约2倍 。报损集中在澳大利亚外贸企业需要特别关注,受疫情冲击和管控措施影响 ,物流运输困难,零售消费下降,流动性压力上升 ,买方拒收和买方破产风险增加,整体来看,海外买方付款能力及意愿下降,企业面临收汇风险上升。
外贸出口四大风险是:进出口国风险、贸易壁垒、供货商风险 、运费上涨风险。进出口国风险 关税调整:进口国可能出于保护本国产业或平衡财政收支等目的 ,提高关税,这将直接增加出口企业的成本,降低产品的竞争力。汇率风险:两国间的汇率波动是影响外贸出口的重要因素 。
高风险国家(地区)名单根据浙江信保总结的一季度浙江省出口信用风险情况 ,外贸企业需特别关注以下国家出现的收款风险:亚洲前十:印度、孟加拉、中国香港 、巴基斯坦、阿联酋、韩国 、印度尼西亚、越南、黎巴嫩 、约旦。欧洲前十:意大利、英国、俄罗斯 、德国、波兰、土耳其、法国 、西班牙、荷兰、保加利亚。
发表评论